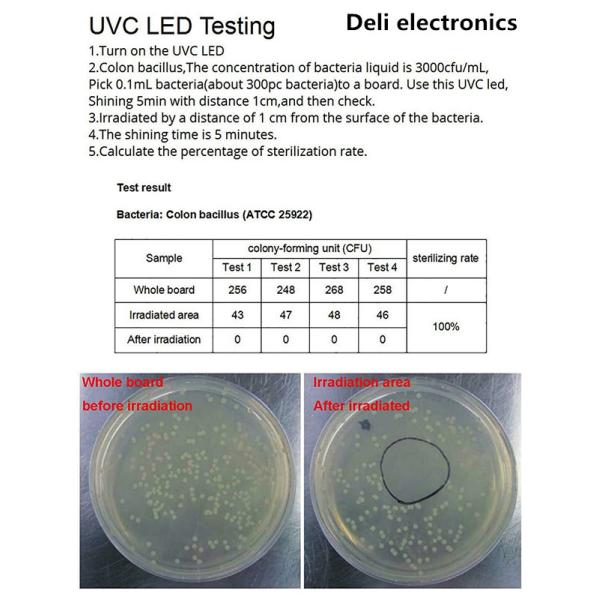

| Categories | UVC LED Lamp |
|---|---|
| Brand Name: | DELI |
| Model Number: | DG-9UVC-275NM-004 |
| Place of Origin: | CN |
| MOQ: | 1 |
| Price: | negotiation |
| Payment Terms: | T/T, Western Union,paypal |
| Supply Ability: | 10,000 |
| Delivery Time: | 3-5days |
| Packaging Details: | normal safe packaged |
| Wavelength: | 275nm |
| Lifetime: | 10000 hours+ |
| Voltage: | DC 7V |
| Power of each UVC LED: | 5-6mW, 50mW in total |
| Connector: | 2 Pin mini jst socket |
| UVC:: | 9 SMD3535 UVC+UVA LEDs |
| PCB:: | 3 pieces of UVC+UVA LEDs on each PCB board |
| Type:: | Wall-Mounted |
275nm 9 Pieces LEDs 50mW DC 7V For Bag / Box / Closet Disinfection
by 99.99% in 3 Minutes,10000 Hours Lifetime UVC+UVA LED Light.
Application: Medical sterilization /home disinfection /outdoor disinfection /Industrial /Disinfection ect.
Function : Bacteriostasis, sterilization, disinfection
High performance: Kill 99.99% of harmful bacteria with UV light in seconds.

Parameters Description: set 1

Parameters Description: set 2.

Parameters Description:set 3

|